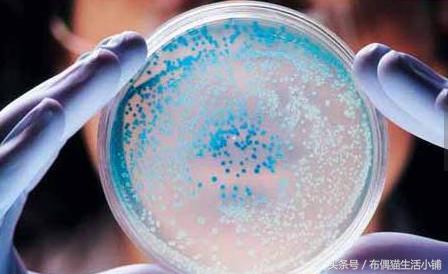
粉扑放在哪不容易滋生细菌,粉饼的粉扑用时间长了会有细菌吗

长期使用的粉扑,实际是需要每次用完后都彻底清洗的。
3天不洗,上面可能会蕴藏4-5万个细菌。
然后你再用这个满含细菌的粉扑画个妆,那岂不是名副其实的细菌妆?
粉扑是细菌的温床,包括一些粉刷,日常生活中,脸部、手部的皮肤暴露在空气中,会吸引空气中的细菌。
而皮肤上的油脂和粉底中的植物成分,则给细菌提供了很好的营养。
再不经常清洗,自然就成了细菌的温床。

上妆小道具“不健康”了,想想你的皮肤还能健康吗?
粉扑上不断累积余粉和皮屑皮脂,潮湿的气候中螨虫更是滋生不断。
所以用了贵价的精华和卸妆乳,发现自己肌肤还是会出现各种问题:闭口粉刺!大毛孔!痘痘!而且妆容也开始不服帖浮粉、卡粉……

你看不见的底妆危害,其实化妆工具才是问题!
同样的,如果脸上有破皮或者损伤,长期接触不干净的粉扑,很容易患上毛囊炎或者化脓。
今天布偶猫就教大家几个清理化妆用品的小技巧,包括海绵粉扑,粉刷,睫毛夹。

海绵粉扑葫芦蛋如何清洗?
第一步:首先用卸妆乳或者洁面乳,直接倒适量于已经沾水的海绵上,使其产生泡沫。
第二步:手掌重复捏放粉扑,这样可以将海绵内的脏污与粉底彻底清理出来。注意,不要用搓揉海绵的方式清洗,这样会使弹性变差,稍微差点的葫芦蛋直接就被揉到报废。(如果你买的粉扑葫芦蛋是便宜货的话,可以考虑用一段时间就换掉。)

第三步:然后再用大量的水冲洗干净。
第四步:用多张纸巾或干净、容易吸水的毛巾,将海绵按压吸干水分。然后放置于阴凉的通风处,使其自然风干即可。
睫毛夹怎么清洗?
第一步:拿出你的吹风机,调到热风,对着睫毛夹吹1-2分钟。

第二步:拿湿纸巾擦拭睫毛夹,就能让睫毛夹恢复干净啦~
粉刷如何清理?
沐浴乳+橄榄油
第一步:在碗里倒入沐浴乳和橄榄油,比例为3:1。

第二步:将粉刷放入碗里,来回打圈。

第三步:粉底溶出来之后,把粉刷放入清水中,慢慢揉搓。

第四步:粉刷洗干净之后,轻轻拧干水,用纸巾把粉扑的毛发顺一下,然后将粉刷放在通风处阴干即可。
好啦这几个小技巧大家学会了吗~
喜欢本文可以为我们点赞转发或者关注我们哦!
布偶猫生活小铺,每天为您带来美妆护肤新资讯~
新手必备的上妆步骤传送门:从零开始学化妆,最全化妆步骤教你画出好看自然的妆容
